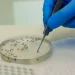
Quatro novos casos de Febre Oropouche são confirmadas em Pernambuco

Uma noite de cultura e gastronomia. Esses foram os ingredientes do lançamento do novo artista homenageado do Movimento Chocolarte. J.Borges entra no hall dos artistas pernambucanos que irão fazer parte da Galeria Chocolarte. O evento aconteceu na noite desta terça-feira (04), na Casa Alma, em Olinda.
A iniciativa contou com a presença da imprensa, representantes governamentais, trade turístico, arquitetos, artistas plásticos e cantores, como, Nena Queiroga, Nega do Babado, Silvério Pessoa, e contou com um pocket show de Mago de Tasso, cantor da nova cena pernambucana. Além dos mestres Mano de Baé, Lúcia de Nuca e Denis de Nuca e o artista plástico Thiago Ilustra.
Idealizado pela Confeitaria do Oliveira, sob a liderança do Chef confeiteiro Matheus Oliveira e seu sócio Leonardo Carvalho, o Movimento Chocolarte tem por objetivo transformar obras icônicas pernambucanas em criações feitas de chocolate. Além da venda de produtos, busca oferecer experiências carregadas de histórias e tradições de Pernambuco, fornecendo a disseminação da cultura do povo através da gastronomia.
Movimento Chocolarte
Idealizado pela confeitaria do Oliveira, sob a liderança do chef confeiteiro Matheus Oliveira e seu sócio Leonardo Carvalho, o Movimento Chocolarte tem por objetivo transformar obras icônicas pernambucanas em criações feitas de chocolate.
O Movimento já homenageou as obras Leão de Nuca, Cabeça da La Ursa customizada por Tiago Henrique (ilustrador) e as Pinturas Rupestres do Vale do Catimbau. O projeto conta com 15 empresas apoiadoras, sendo 14 pernambucanas.